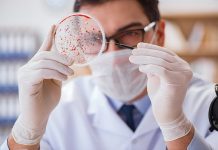
Лабораторная диагностика венерических болезней

Врачи онкологи-маммологи: что лечат, как проходит прием
Врачи онкологи-маммологи занимаются лечением опухолей молочных желез. Также специалисты помогают предупреждать раковые заболевания (обследования, профилактика).
Посещение онколога-маммолога часто рекомендуется как мера профилактики опухолей. При наличии...
Несколько интересных фактов о коньяке
Коньяк - напиток, о котором обычный человек знает очень мало. Ведь именно этот напиток связан со множеством мифов, о нем можно найти немало интересных...
Как выбрать хороший инструмент грумеру
Как выбрать хороший инструмент грумеру? Этим вопросом задаются, в частности, те, кто планирует заниматься грумингом. Что же такое груминг? Это профессиональный уход за собакой....
Критерии выбора унитаза
В своей жизни, каждый человек довольно продолжительное время проводит в туалете. Именно поэтому вопрос обустройства уборной комнаты должен быть решен с максимальной серьезностью. Основным...
Быстрый способ купить диплом университета
Как быстро купить диплом университета?
Наверняка вы попали сюда, потому что вам нужны документы, подтверждающие наличие образования. Возможно, вы утратили свой настоящий диплом или же...
Достоинства и особенности современного протезирования
Сегодня все больше людей сталкиваются с различными проблемами, заболеваниями зубов. К сожалению, зубы не вырастают снова, не восстанавливаются сами, поэтому внимание практически всего мира...
Как нужно подготовиться к визиту в стоматологию
Да, к стоматологу каждый человек, попадает не так часто. Но каждый раз такое посещение будет достаточно волнительным мероприятием. Стоит подготовиться к такому приему, чтобы...
Почему стоит выбрать внутрипольные конвекторы
Во многих частных домах система отопления устаревает или остается слишком замороченной и дорогостоящей. Можно, конечно, отапливать дом печкой, камином или газом, но это не...
Как часто нужно посещать стоматолога
Чтобы зубы всегда были в порядке, необходимо осуществлять за ними уход и регулярно посещать стоматологию. Лучше когда стоматология может предложить услуги по современным технологиям,...
Лабораторная диагностика венерических болезней
Так как большинство венерических болезней имеют схожие симптомы проявления, помимо осмотра венеролога необходимо сдать лабораторные анализы, которые подтвердят или опровергнут поставленный венерологом диагноз. После...